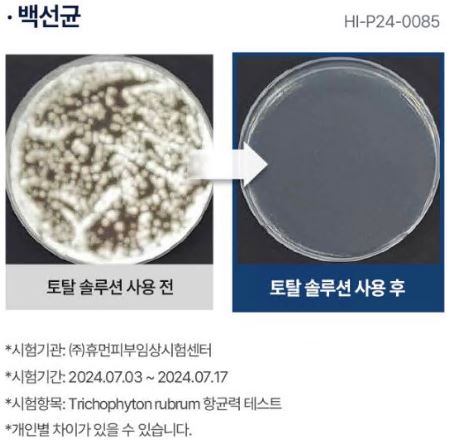
김수로-무좀약-라센털

최근 무좀을 가지고 있는 분들께 희망적인 소식이 전해졌는데요. 배우 김수로가 극찬한 것으로 알려진 라셀턴 무좀 발톱 세럼의 탁월한 효과에 대해 자세히 알아보겠습니다. 이 제품의 공식 명칭은 "라셀턴 풋 솔루션 리페어 앰플"로, 발톱 무좀 관련 문제들을 효과적으로 개선할 수 있는지 확인해 보실 수 있습니다. 또한, 실제 사용자들의 라셀턴 후기를 통해 정말 효능이 좋은지 살펴보도록 하겠습니다.
라셀턴 발톱 세럼의 주요 특징


"라셀턴" 무좀 세럼의 이름에는 특별한 의미가 담겨 있습니다. "라(RA)"는 고대 이집트에서 태양신으로 여겨졌던 신을 상징하며 영원한 생명력을 뜻합니다. "셀(CEL)"은 영어 단어 "세포(Cell)"에서 영감을 얻었고, "턴(TURN)"은 변화를 의미합니다. 이처럼 라셀턴은 건강한 피부 회복을 추구하는 더마코스메틱 브랜드로 자리 잡고 있습니다.
이 제품은 "피부 관리의 고민을 해결하겠다"는 바람에서 시작되었습니다. 라셀턴은 단순한 화장품을 넘어, 손상된 피부 장벽을 회복하고 일상에 지친 피부에 활력을 부여하기 위해 지속적으로 연구와 분석을 거듭합니다. 특히 엄격히 선별된 성분만을 사용하며, 유해 성분은 철저히 배제해 전 연령층이 안심하고 사용할 수 있는 제품 생산에 중점을 두고 있습니다.
라셀턴 발톱 세럼은 일반적인 화장품이 아닌 식품의약품안전처로부터 정식 허가받은 의약외품입니다. 세균 억제 기능을 갖추고 있으면서도, 손발톱 피부에 촉촉함을 유지할 수 있도록 도움을 줍니다.
라셀턴 효과 및 성분 분석


라셀턴 발톱 세럼은 문제성 손발톱 개선에 도움을 주는 특화된 제품으로, 소비자들에게 큰 주목을 받고 있습니다. 출시 이후 누적 판매량은 25만 개를 돌파했으며, 한때 2분당 1개꼴로 판매될 정도로 인기를 끌었습니다.


제품의 핵심 성분으로는 국내 최초로 특허받은 요엽후박나무 추출물, 티트리 잎 오일, 라벤더 오일 등이 포함되어 있으며, 이를 통해 문제성 손발톱 관리에 탁월한 효과를 발휘합니다. 또한 최근에는 액체 제형의 불편함을 보완하여, 네일 패치 형태로 제품 라인업을 확장하며 소비자층을 넓히고 있습니다.
라셀턴 무좀 발톱 세럼의 주요 성분
- 히알루론산: 피부에 깊은 보습감 제공 및 손발톱 표면 강화
- 비오틴: 영양 부족으로 인한 손톱 및 발톱 손상 복구
- D-판테놀: 피부 재생 촉진
"라셀턴"은 철저히 자연 유래 성분으로만 만들어져 기존 화학 성분에 민감한 사용자에게도 적합합니다. 특히, 각질층 제거와 세균 억제 기능, 백선균 제거 효과가 검증되어 손발톱 질환 예방 및 관리에 높은 신뢰를 얻고 있습니다.
제품 사용법
라셀턴 발톱 세럼의 사용법은 다음과 같습니다
- 손이나 발을 미온수로 깨끗이 씻고 물기를 완전히 제거합니다.
- 스포이트로 적정량(1~2방울)을 손톱이나 발톱 부위에 떨어뜨립니다.
- 부드럽게 발라 영양분이 균일하게 흡수되도록 합니다.
현재 라셀턴 무좀 앰플의 공식 판매처 기준으로 1개월분 1개 제품은 약 32,000원 정도의 할인된 가격으로 구매할 수 있습니다. 다만 다양한 판매처의 가격을 꼼꼼히 비교하여 본인에게 가장 유리한 조건에서 구매하는 것이 좋습니다.
라셀턴 발톱 무좀 세럼은 독특한 거품 세척 기술을 활용하여 노폐물 제거 효능을 높이는 데 도움을 줍니다. 이 제품은 가벼운 워터 제형으로 빠르게 흡수되고, 풍성한 거품 효과를 제공하며 발 상태에 따라 세정력이 체감될 수 있습니다. 참고로 거품이 적게 발생한다고 해서 제품의 세정력이 떨어지는 것은 아니니 안심하셔도 됩니다.
라셀턴 후기와 사용 경험 엿보기

라셀턴 무좀 발톱 세럼을 사용한 소비자들의 후기를 살펴보면, 제품이 다양한 발 건강 문제에 긍정적인 도움을 준 사례들이 확인됩니다. 다음은 실제 라셀턴 후기들을 조사하여 요약한 내용이니 참고하시면 도움이 될것입니다.
- 편리한 사용 방식: 스포이드 형태라서 손에 묻히지 않고 바로 사용 가능하며, 갈라지고 착색된 발톱 개선에도 도움이 되었습니다.
- 효과가 좋아 라셀턴 후기 남겨 보네요. 효과적인 곰팡이균 개선: 발바닥과 발가락 사이의 곰팡이균 증상이 나아졌으며, 지속 사용 후 추가 개선 효과를 기대할 수 있었다고 합니다.
- 발 건강 개선 사례: 발에 땀이 많아 발톱 끝이 변색되었지만, 꾸준히 제품을 사용한 결과 문제가 개선되었다고 합니다.
- 촉촉한 흡수와 쾌적한 향: 손발톱이 건조한 편이라 관리가 필요했는데, 이 제품이 촉촉하게 흡수되며 향도 좋아 만족했다는 의견이 많습니다.
라셀턴 무좀 발톱 세럼은 먼저 손과 발을 미온수로 깨끗이 씻고 완전히 건조하는 것이 중요합니다. 이후, 앰플을 손발톱 부위에 1~2방울 떨어뜨립니다. 발톱의 경우 안쪽부터 끝까지 부드럽게 펴 바르며, 이를 통해 영양분이 고르게 퍼지도록 해야 효과를 극대화할 수 있습니다. 라셀턴은 간단하면서도 효과적인 관리를 제공합니다. 건강한 발톱 관리를 원한다면 꾸준히 사용해 보는 것이 좋습니다.

